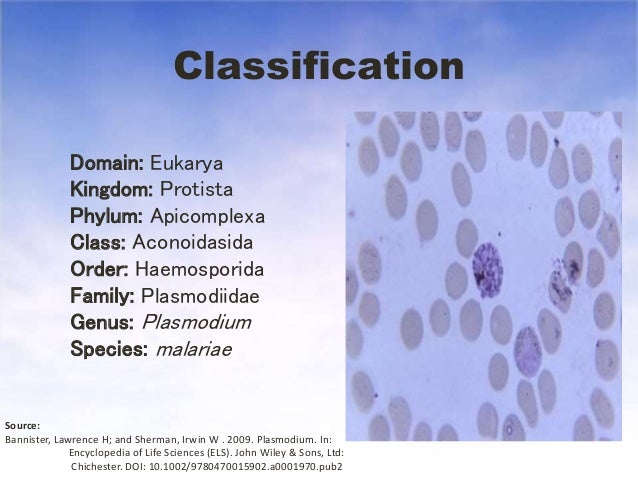
Plasmodium malariae

Plasmodium malariae est une des espèces de parasites responsables du paludisme chez l’homme. On le lie étroitement à Plasmodium falciparum et Plasmodium vivax qui sont responsables de la plupart des infections malariques chez l’être humain. Bien que réparti sur toute la planète, il ne provoque que des « accès paludiques bénins » et est bien moins dangereux que les autres Plasmodium. Il est aussi le seul à provoquer des fièvres quartanes (tous les quatre jours) au lieu de fièvres tertianes (tous les trois jours).
Signes et symptômes
Ce Plasmodium cause une infection durable et chronique qui, dans certains cas, peut durer la vie entière. Parfois, il peut causer des complications sérieuses telles que le syndrome néphrotique.
En raison d’une similitude d’aspect, en tant que microbes pathogènes, P. malariae et P. knowlesi sont souvent mal diagnostiqués comme étant du paludisme. L’analyse moléculaire est habituellement exigée pour un diagnostic précis.
Voir aussi
Plasmodium
Références
Liens externes
- Portail de la microbiologie
- Portail de la parasitologie